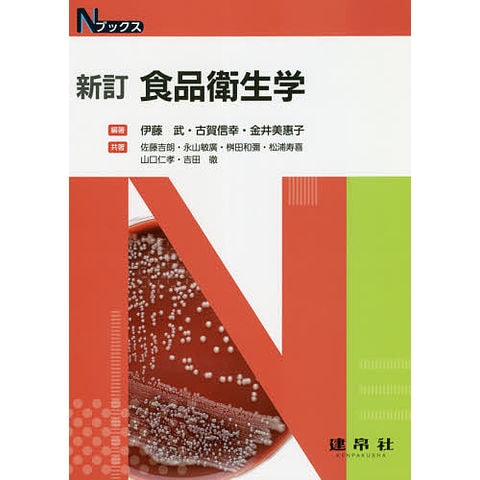

1/20
時点_ポイント最大6倍
食品衛生学/伊藤武/古賀信幸/金井美惠子
販売価格
2,970
円 (税込)
送料無料
- 出荷目安:
- 1~3日で発送予定
たまるdポイント(通常) 27
+キャンペーンポイント(期間・用途限定) 最大5倍
※たまるdポイントはポイント支払を除く商品代金(税抜)の1%です。
※表示倍率は各キャンペーンの適用条件を全て満たした場合の最大倍率です。
各キャンペーンの適用状況によっては、ポイントの進呈数・付与倍率が最大倍率より少なくなる場合がございます。
dカードでお支払ならポイント3倍
各キャンペーンの適用状況によっては、ポイントの進呈数・付与倍率が最大倍率より少なくなる場合がございます。
- 商品情報
- レビュー
伊藤武古賀信幸金井美惠子
建帛社
Nブックス
ISBN:4767906466/9784767906461
発売日:2020年05月
建帛社
Nブックス
ISBN:4767906466/9784767906461
発売日:2020年05月